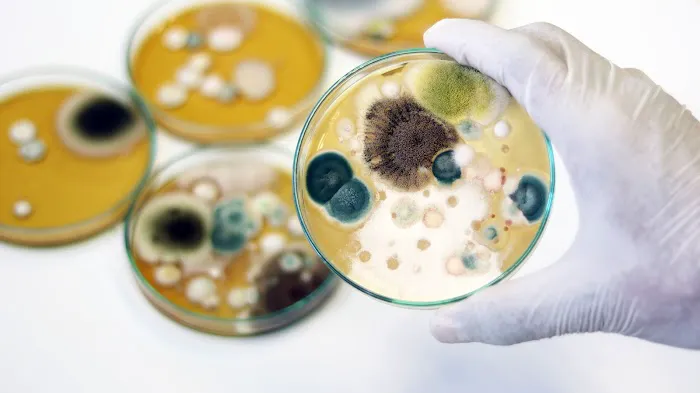
Beam Construction and Restoration Inc Picture 4

Beam Construction and Restoration Inc Photos

Beam Construction and Restoration Inc Introduce
For homeowners in California's Central Valley, the roof is more than just a cover for their home; it's a vital defense against the intense summer sun and the occasional heavy rains. Keeping it in top condition is essential for protecting a home’s structural integrity and energy efficiency. Finding a reliable, professional roofing contractor who understands these specific regional needs is a crucial task. In Fresno, residents have a trusted partner in Beam Construction and Restoration Inc, a company that provides expert roofing services alongside a comprehensive range of construction and restoration solutions. They are a local business with a strong reputation for quality workmanship and a customer-first approach, making them a go-to resource for anyone needing roofing work, whether it's a small repair or a complete replacement.
Beam Construction and Restoration Inc operates with a deep understanding that a roof is a significant investment. Their team of professionals is dedicated to providing solutions that are not only effective but also durable and long-lasting. They take a consultative approach, working closely with homeowners to assess their needs, discuss the best options, and provide transparent estimates. This process ensures that clients are well-informed and confident in the decisions they are making for their home. Unlike some contractors who may focus solely on the job, this company emphasizes the entire client experience, from the initial phone call to the final project walkthrough. They are known for their professionalism and their ability to complete projects on schedule, which is a testament to their efficient and organized workflow. Their expertise extends beyond just roofing, as they are a full-service general contractor, giving them a unique advantage when a roofing project uncovers other issues, such as structural damage or water damage.
This dual focus on both roofing and restoration makes Beam Construction and Restoration Inc a valuable resource for the Fresno community. They are equipped to handle projects that are not just about a simple shingle replacement, but about the bigger picture of home health and safety. Their ability to manage everything from a minor leak repair to a major reconstruction after storm damage positions them as a comprehensive and reliable partner for any homeowner. The peace of mind that comes from knowing you have a skilled and trustworthy team on your side is immeasurable, and it is this feeling that Beam Construction and Restoration Inc strives to provide with every project they undertake. Their commitment to quality and customer care has solidified their place as a leading contractor in the Central Valley, offering a much-needed service with a high degree of integrity and skill.
Beam Construction and Restoration Inc is conveniently located at 2546 N Business Park Ave, Fresno, CA 93727, USA. This location in a professional business park provides easy access for their team to serve clients throughout the Fresno metropolitan area and the wider Central Valley. Their presence in this specific area makes them easily reachable and well-positioned for quick dispatch, which is especially important for emergency roof repairs. Being centrally located allows them to effectively manage logistics and ensure timely arrival at job sites, whether in north or south Fresno. This accessibility is a key factor in their ability to provide prompt and efficient service, which is a major concern for homeowners with damaged roofs. They are a true local business, deeply familiar with the region's geography, infrastructure, and common construction styles. This local knowledge allows them to provide more accurate estimates and more effective solutions tailored to the specific needs of Fresno residents.
As a company with deep roots in the community, their physical location is more than just an address. It represents a central hub for their operations, where they coordinate projects, store equipment, and meet with clients. This local presence is a significant benefit for homeowners who prefer to work with a contractor they can easily contact and meet in person. Their proximity to major transportation routes ensures that they are never far from a project, which translates into better communication and a more hands-on approach to every job. For anyone in the Central Valley, having a reliable and accessible roofing contractor like Beam Construction and Restoration Inc is a valuable asset, providing confidence and convenience from start to finish.
Beam Construction and Restoration Inc provides a wide array of services designed to address all aspects of roofing and general home restoration. Their expertise covers both planned projects and emergency situations, making them a versatile partner for homeowners. Their services include:
- Roof Repair: Addressing leaks, damaged shingles, and other issues to extend the life of your existing roof and prevent further damage.
- Roof Replacement and Installation: Expertly installing new roofing systems, from tear-offs to new construction, using high-quality materials to ensure durability and protection.
- Storm Damage Restoration: A critical service that involves assessing and repairing roofs damaged by severe weather, including wind, rain, and hail. They work to quickly secure the property and restore the roof to its pre-damage condition.
- Water Damage Restoration: Often working in tandem with their roofing services, they are skilled at handling interior water damage that results from a roof leak, providing a full-service solution from the top down.
- General Contracting: As a full-service general contractor, they are able to manage and execute a wide range of home improvement and repair projects beyond just the roof, offering a single point of contact for homeowners with multiple needs.
- Emergency Services: Providing a fast response for urgent situations that require immediate attention, such as a severe roof leak or a tree falling on the roof. They are equipped to secure the property and begin the restoration process around the clock.
Beam Construction and Restoration Inc has built a strong reputation in the Fresno area by focusing on key qualities that matter most to homeowners. Their commitment to these standards is what makes them a preferred choice for roofing and restoration projects. Some of their most notable features and highlights include:
- Comprehensive Services: As a general contractor with a specialization in roofing and restoration, they can handle a wide variety of projects, offering a one-stop-shop for homeowners. This eliminates the need to hire multiple contractors for a single issue.
- Commitment to Customer Satisfaction: The company is known for its excellent customer service. They are transparent, communicative, and dedicated to walking customers through every step of the repair or restoration process.
- Professional and Highly Trained Team: Their staff is composed of highly trained and certified professionals who are skilled in their respective trades. This expertise ensures that all work, from a simple repair to a complex restoration, is completed to the highest standards.
- Honest and Fair Pricing: Customers have noted that the company provides fair and reasonable estimates and sticks to the price they quote, which is a major factor in building trust with clients.
- Timely and Efficient Work: Punctuality and efficiency are hallmarks of their service. They complete projects on time, respecting the client's schedule and minimizing disruption.
- Warranty and Guarantees: They stand by their work with available warranties, giving homeowners peace of mind that their investment is protected and that the results will last.
For residents in the Fresno area, getting in touch with Beam Construction and Restoration Inc is easy and convenient. You can contact their team by calling their main phone number, (559) 433-3400. They also provide a mobile number, +1 559-433-3400, for direct and responsive communication, which is especially important for urgent roofing needs. Their physical office is located at 2546 N Business Park Ave, Fresno, CA 93727, USA. These contact points, coupled with their emergency services, ensure that help is always just a phone call away. Their accessibility and local presence make them a reliable and trusted partner for any homeowner dealing with roofing or restoration issues.
For the people of Fresno and the Central Valley, Beam Construction and Restoration Inc is an ideal choice for any roofing or restoration needs. The local climate, which features intense sun and can lead to rapid roof degradation, necessitates a contractor who understands these specific environmental challenges. This company's combination of specialized roofing expertise and broad general contracting capabilities means they are uniquely equipped to handle a full spectrum of home issues, from a simple leak to major structural repairs. Their commitment to transparent communication, fair pricing, and high-quality workmanship ensures a positive and stress-free experience for the homeowner. By choosing Beam Construction and Restoration Inc, locals are not just hiring a contractor; they are partnering with a team that is deeply invested in the community and dedicated to protecting one of their most valuable assets—their home. Their reputation for honesty and professionalism, combined with a quick and reliable service, makes them the definitive choice for any resident seeking a dependable and skilled partner for their roofing and restoration projects.
Beam Construction and Restoration Inc Services
Water Damage Restoration Service
- Fire damage cleanup & repair
- Flood cleanup
- Flood restoration
- Mold cleaning
- Mold damage restoration
- Mold inspection
- Mold mitigation
- Mold remediation
- Remodeling
- Sewage cleanup
- Water damage-related cleanup & repair
- Water damage-related mold removal
- Water removal
Fire Damage Restoration Service
- Air Conditioning Systems
- Air Conditioning Units
- Basement Flooding
- Boarding Up
- Burst Pipes
- Comprehensive Assessment
- Comprehensive Cleaning
- Comprehensive Restoration
- Construction And Restoration
- Crawl Space Cleanup
- Damage Inspect
- Damage Recovery
- Emergency Restoration Services
- Entire Restoration
- Fire And Smoke Damage
- Free Estimate
- Frozen Pipes
- Full Restoration
- Hurricane Damage
- Hvac System
- Insurance Assistance
- Mold Inspection
- Mold Remediation
- Mold Removal And Restoration
- Preventive Measures
- Property Damage
- Remove Debris
- Restoration Project
- Restore Your Property
- Roof Leaks
- Sewage Cleanup
- Smoke And Soot Removal
- Storm Damage Repair
- Storm Damage Restoration
- Structural Damages
- Thorough Cleaning
- Water Damage Restoration
- Water Extraction And Drying
- Water Heaters
- Water Removal
Beam Construction and Restoration Inc Details
Accessibility
- Wheelchair accessible entrance
- Wheelchair accessible parking lot
Beam Construction and Restoration Inc Location
Beam Construction and Restoration Inc
2546 N Business Park Ave, Fresno, CA 93727, USA
Beam Construction and Restoration Inc Reviews
More Water Damage Restoration Near Me
Roto-Rooter Plumbing & Water Cleanup4.0 (127 reviews)5869 E Brown Ave, Fresno, CA 93727, USA
SERVPRO of Fresno Southeast4.0 (27 reviews)5816 E Princeton Ave, Fresno, CA 93727, USA
ALL AMERICAN CONSTRUCTION4.0 (3 reviews)5804 E Brown Ave, Fresno, CA 93727, USA
Rainbow Restoration of East Fresno5.0 (29 reviews)2980 N Sunnyside Ave #101, Fresno, CA 93727, USA
Olsen Construction and Restoration Company Inc.5.0 (17 reviews)2976 N Argyle Ave, Fresno, CA 93727, USA
Everu2019s Painting5.0 (89 reviews)5878 E Ramona Ave, Fresno, CA 93727, USA
Fresno Mold Removal & Restoration5.0 (22 reviews)5519 E Hedges Ave, Fresno, CA 93727, USA
PuroClean of East Fresno0.0 (0 reviews)5494 E Lamona Ave Suite 134, Fresno, CA 93727, USA
CPR Carpet & Restoration4.0 (22 reviews)3913 N Ann Ave, Fresno, CA 93727, USA
Heritage Construction5.0 (1 reviews)1227 Barstow Ave, Clovis, CA 93612, USA
CR Painting4.0 (54 reviews)74 W Beverly Ave, Clovis, CA 93612, USA
Trademark - General Contractor, home, bathroom, kitchen remodel4.0 (190 reviews)4674 E Weathermaker Ave, Fresno, CA 93703, USA
Categories
Top Visited Sites
My Dry Team Restoration Services4.0 (48 reviews)
Xtreme Steam Carpet & Tile Cleaning4.0 (188 reviews)
Americlean of Iowa, LLC4.0 (221 reviews)
ServiceMaster by BTM4.0 (113 reviews)
Armor Restoration and Building4.0 (15 reviews)
Fireservice Emergency Disaster Response4.0 (184 reviews)Top Water Damage Restoration Searches
Trending Damage Repair Guides Posts
How to Prevent Water Damage in Older Homes: Essential Tips for Protection
How to Repair Water-Damaged Drywall
How to Handle Water Damage From Burst Water Heaters – Cleanup, Repair & Prevention
How to Restore Water-Damaged Books and Papers: Expert Tips
Water Damage Restoration for Retail Stores: What You Need to Know
How Water Damage Affects Your Home’s Value and Ways to Prevent It
